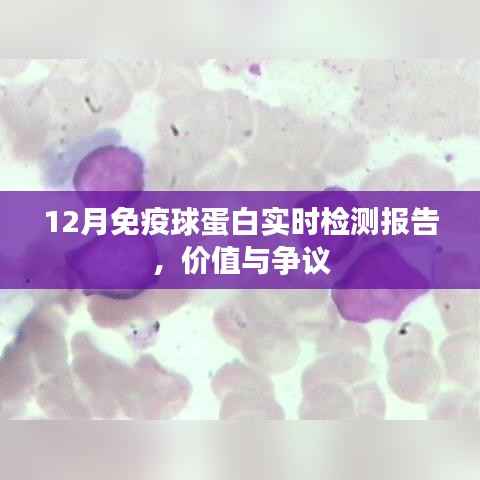

独家攻略揭秘山景区绝美风光,让你一探究竟!
山景区以其独特的自然风光和人文景观吸引着无数游客,如何充分利用时间,尽情领略山景区的魅力?本文将为你提供一份详尽的旅游攻略,带你探索山景区之美。目的地选择你需要确定山景区的具体地点,国内有许多著名的山景区,如黄山、泰...
重庆到广州旅行指南,完美行程规划!
重庆与广州,两城之间的旅行总能给人带来别样的体验,从重庆的繁华都市风光,到广州的现代都市与传统文化的交融,这样的旅程充满了期待,以下是一份从重庆返回广州的旅游攻略,希望能为你的旅程提供一些参考。重庆游览攻略在重庆,你...
人工智能风口公司排行榜揭晓,谁是行业领军者?
随着科技的飞速发展,人工智能(AI)已经渗透到各行各业,成为新时代的风口,众多企业纷纷投身于人工智能领域,竞争日益激烈,本文将介绍一些在人工智能领域表现突出的公司,并对其进行排名。谷歌谷歌作为全球的科技巨头,一直在人...
晋城今日交通实时播报,堵车热点一览无余!
最新消息随着城市的发展和人口的增加,交通问题一直是晋城居民关注的焦点,关于晋城哪里堵车的消息引起了广大市民的关注,本文将为您提供晋城今天的交通状况以及最新的堵车消息。晋城交通概况晋城市位于山西省东南部,是一个历史悠久...
01月公务员报考热门比例分析,最新趋势解读
随着社会的不断发展和进步,公务员职业的稳定性和良好的福利待遇吸引了越来越多的年轻人投身其中,每年的公务员考试都是一场盛大的盛宴,而每年的报考比例更是反映了社会的热点和趋势,本文将为您详细解读01月公务员热门报考比例,...
12月免疫球蛋白实时检测,报告价值与争议探讨
一、引言随着医学技术的不断进步,免疫球蛋白实时检测在疾病诊断与治疗过程中的作用日益凸显,12月的免疫球蛋白实时检测报告作为这一领域的代表性成果,引起了广泛的关注和讨论,本文将围绕这份报告,探讨其所带来的正面和负面观点...
漳州公交实时查询app,探索自然美景之旅,带你远离尘嚣,发现内心的宁静与平和之旅
在这个快节奏的时代,我们时常被工作和生活的压力压得喘不过气来,为了寻找内心的平静和宁静的角落,越来越多的人选择踏上探索自然美景的旅程,而今天,我要向大家介绍一款神器——12月18日全新上线的漳州公交车位置实时查询ap...
香港最准最快资料免费:网络时代的数据风向标
网络时代的信息革命正在深刻地改变着香港社会的面貌,香港,作为全球重要的金融中心和信息枢纽,数据的流动性和准确性显得尤为重要,从商业决策到民众日常生活,每一个环节都离不开数据的支持,数据的获取、分析、应用和创新,已经成...
实用指南,获取与解读光山新闻资讯的热门消息及实用指南(2024年12月更新)
一、引言随着信息时代的发展,新闻资讯已成为我们日常生活中不可或缺的一部分,对于光山地区的居民来说,了解本地的新闻热门消息对于融入社区生活、把握时事动态具有重要意义,本文将指导初学者和进阶用户如何获取并解读光山新闻,确...
揭秘未来游戏趋势,解析热门PC游戏预测与我的观点,展望2024年12月9日热门游戏动态
随着科技的飞速发展,电脑游戏已成为人们娱乐生活的重要组成部分,特别是在当下这个数字化时代,PC游戏的发展日新月异,每年都有新的热门游戏涌现,本文将聚焦于对2024年12月9日热门PC游戏的猜测,并阐述我的观点,在此之...

蜀ICP备2022005971号-1
蜀ICP备2022005971号-1